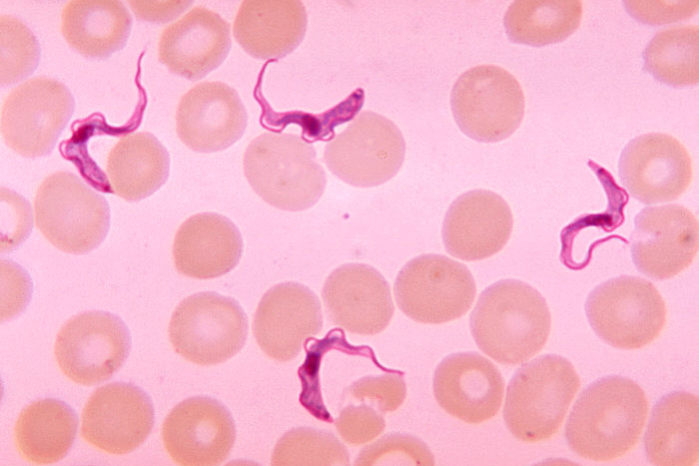
Trypanosoma is shown as an example of what people expect parasites to look like. Nonetheless, Valley Fever is also a parasitic disease.

Certain words are inherently offensive. In the discussion of any disease, people don’t like thinking about terrible consequences. In Valley Fever specifically, we have recently been told the term “parasite” is offensive.
Some have said they will readily admit they have Valley Fever, but certainly not any kind of parasite. There are people incorrectly hung up on the idea that a parasite has to be a worm, and that if something is not worm-shaped it can never be a parasite. Or perhaps a parasite would somehow be worse or less socially acceptable than a fungal infection.
The correct thought needs to be that if something feeds off of you as a source of sustenance while you are alive, it is a parasite. Whether the parasite is over the skin or deep within an organ does not matter. Ticks can be parasites. Worms can be parasites. Fungi can be parasites.
When fungi from the species Coccidioides are causing Valley Fever, people should recognize them as fungal parasites. As much as Valley Fever Survivor has done to share information, we were not the ones who started labeling it as such. This term was common in the scientific literature for decades.
In fact, when considerations were made to regulate Valley Fever as a biological weapon, what was said about it to emphasize its importance? Consider these comments from the pages of the Journal of Applied Microbiology:
Coccidioides immitis is the most virulent of the primary fungal pathogens of humans and other animals. As such, it is the only fungal aetiological agent designated as Biosafety Level 3 in Biosafety in Microbiological and Biomedical Laboratories, 3rd edn…
The binomial [species name], Coccidioides immitis, was given to the organism because the parasitic, or spherule phase of the fungus in tissue resembled members of the protozoa from order Coccidia [which is another type of parasite], and because [of] the fatal consequences of the involved case (Coccididioides=Coccidium‐like; immitis= not mild).
Coccidioides immitis is the fungus that causes Valley Fever/coccidioidomycosis. It was not just mentioned here as the worst fungi to cause disease for humans and animals. It was not just mentioned as being a parasite. From the moment the species received a name, that name was based on its superficial similarity to Coccidia parasites. Furthermore, the parasitic nature of Coccidioides was a part of the consideration for its regulation as a Select Agent of Bioterrorism.
So is Valley Fever caused by a fungal parasite? Absolutely yes.
To people understand the disease, we would love for everyone to know that Valley Fever was regulated as a biological weapon. Everyone might be more concerned if they also knew it was a parasitic disease, even if the thought is offensive.
Deep offense can take many forms. Does it count as an example to see the 2021 Lombardi trophy tossed by Tom Brady from a boat to other players? The daughter of the silversmith who created the first trophy was so disturbed by seeing the trophy “disrespected” that she said she “didn’t sleep for the past two nights” when interviewed. The report did not say whether she expressed embarrassment for admitting this in the first place. After all, it was far from a matter of life and death.
Weightier matters could be even more offensive even if they were not the day’s top story. Consider Valley Fever. Perhaps having a fungus grow in American soil, float through the air, and infect thousands of people annually with a disease severe enough to be regulated as a biological weapon would also offend people. Perhaps the toxic treatments and constant diagnostic failures would also be offensive. Perhaps the sense of offense would grow when considering it is caused by an incurable, debilitating and deadly fungal parasite.
The fact that people are shocked by the term or deny it outright shows how weak public education has been on this matter.
If the truthful but offensive word “parasite” were used more often, the fight against Valley Fever might get more of the attention it deserves.
Bioterrorism document source:
Dixon DM. Coccidioides immitis as a Select Agent of bioterrorism. J Appl Microbiol. 2001 Oct;91(4):602-5.
Trypanosoma sp. parasitic image credit:
CDC/Dr. Myron G. Schultz